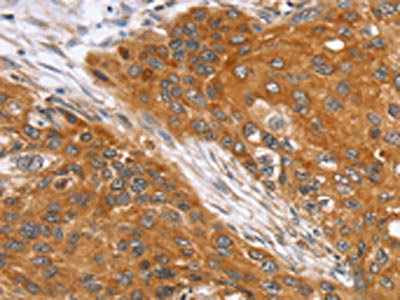

SLC25A13 Antibody
-
中文名稱:SLC25A13兔多克隆抗體
-
貨號(hào):CSB-PA037067
-
規(guī)格:¥1100
-
圖片:
-
The image on the left is immunohistochemistry of paraffin-embedded Human esophagus cancer tissue using CSB-PA037067(SLC25A13 Antibody) at dilution 1/35, on the right is treated with fusion protein. (Original magnification: ×200)
-
The image on the left is immunohistochemistry of paraffin-embedded Human brain tissue using CSB-PA037067(SLC25A13 Antibody) at dilution 1/35, on the right is treated with fusion protein. (Original magnification: ×200)
-
Gel: 8%SDS-PAGE, Lysate: 40 μg, Lane 1-2: Mouse liver tissue, hepg2 cells, Primary antibody: CSB-PA037067(SLC25A13 Antibody) at dilution 1/450, Secondary antibody: Goat anti rabbit IgG at 1/8000 dilution, Exposure time: 20 seconds
-
-
其他:
產(chǎn)品詳情
-
Uniprot No.:
-
基因名:SLC25A13
-
別名:SLC25A13; ARALAR2; Calcium-binding mitochondrial carrier protein Aralar2; Citrin; Mitochondrial aspartate glutamate carrier 2; Solute carrier family 25 member 13
-
宿主:Rabbit
-
反應(yīng)種屬:Human,Mouse
-
免疫原:Fusion protein of Human SLC25A13
-
免疫原種屬:Homo sapiens (Human)
-
標(biāo)記方式:Non-conjugated
-
抗體亞型:IgG
-
純化方式:Antigen affinity purification
-
濃度:It differs from different batches. Please contact us to confirm it.
-
保存緩沖液:-20°C, pH7.4 PBS, 0.05% NaN3, 40% Glycerol
-
產(chǎn)品提供形式:Liquid
-
應(yīng)用范圍:ELISA,WB,IHC
-
推薦稀釋比:
Application Recommended Dilution ELISA 1:2000-1:5000 WB 1:500-1:2000 IHC 1:25-1:100 -
Protocols:
-
儲(chǔ)存條件:Upon receipt, store at -20°C or -80°C. Avoid repeated freeze.
-
貨期:Basically, we can dispatch the products out in 1-3 working days after receiving your orders. Delivery time maybe differs from different purchasing way or location, please kindly consult your local distributors for specific delivery time.
-
用途:For Research Use Only. Not for use in diagnostic or therapeutic procedures.
相關(guān)產(chǎn)品
靶點(diǎn)詳情
-
功能:Mitochondrial and calcium-binding carrier that catalyzes the calcium-dependent exchange of cytoplasmic glutamate with mitochondrial aspartate across the mitochondrial inner membrane. May have a function in the urea cycle.
-
基因功能參考文獻(xiàn):
- There was a correlation between SLC25A13 gene mutations distribution and the GGT level in infants with neonatal intrahepatic cholestasis caused by citrin deficiency PMID: 28516797
- All neonates have harbored mutations of the solute carrier family 25, member 13 protein (SLC25A13) gene, suggesting the SLC25A13 gene probably underlie the neonatal intrahepatic cholestasis caused by citrin deficiency (NICCD). PMID: 29419856
- These findings enriched the SLC25A13 mutation spectrum and brought new insights into the geographic distribution of the variations and genotypes, providing reliable evidences for Neonatal intrahepatic cholestasis caused by citrin deficiency definite diagnosis and for the determination of relevant molecular targets in different Chinese areas. PMID: 27405544
- Upregulation of GLUD1 and SLC25A13 was associated with tumor aggressiveness and poorer prognosis in colorectal cancer patients. PMID: 27924922
- The remaining five patients were diagnosed with neonatal intrahepatic cholestasis due to citrin deficiency, and have respectively carried mutations of the SLC25A13 gene including [c.851-854delGTAT+c.851-854delGTAT], [c.851-854delGTAT+IVS6+5G>A], [c.851-854delGTAT+IVS16ins3kb], [c.851-854delGTAT+IVS6-11A>G] and [c.851-854delGTAT+c.1638-1660dup23] PMID: 28981931
- The features of AGC1 structure and function in physiology and pathology, regulation by calcium, and dependency on mitochondrial membrane potential are reviewed. Review. PMID: 27132995
- the present study reported on clinical and molecular investigations of an infant with NICCD, who was confirmed to be a compound heterozygote of the c.851_854del4 mutation and a novel large deletion c.1019_1177+893del in the SLC25A13 gene. PMID: 27779681
- The large deletion enriched the SLC25A13 mutation spectrum, and its identification supported the concept that cDNA cloning analysis, along with other molecular tools such as semiquantitative PCR, could provide valuable clues, facilitating the identification of obscure SLC25A13 deletions. PMID: 27127784
- Data indicate that the patient was a compound heterozygote carrying c.851_854delGTAT and IVS16ins3kb mutations of the mitochondrial carrier citrin protein (SLC25A13) gene, which were respectively inherited from his mother and father. PMID: 27577219
- Structure of the calcium bound and calcium free N- and C-terminal domains is described, elucidating the mechanism of calcium regulation. PMID: 25410934
- This study aims to screen for five prevalent SLC25A13 mutations, to calculate the mutation carrier rate in Guangdong. PMID: 25110155
- we reviewed the English literature on mutations in the SLC25A13 gene, and its genotype-phenotype correlations to provide valuable insights into the molecular genetic background of citrullinemia--{REVIEW} PMID: 24508627
- Mutation screening of the SLC25A13 gene revealed the compound heterozygous mutations c.1081C>T (p.R361*) and c.74C>A (p. A25E) which confirmed the diagnosis of NICCD. The nonsense mutation c.1081C>T (p.R361*) is novel. PMID: 25365849
- Point mutation of ASS1, ASL and SLC25A13 is associated with citrullinemia. PMID: 24927999
- Identification of novel SLC25A13 gene mutations in East Asian patients with citrin deficiency. PMID: 24069319
- Analysis of the SLC25A13 gene sequence. PMID: 23053473
- Report frequency SLC25A13 mutations in the Thai population and estimate prevalence of citrin deficiency. PMID: 24282362
- The SLC25A13 mutation spectra among the three regions of China were different, providing a basis for the improvement of diagnostic strategies and interpretation of genetic diagnosis. PMID: 23901231
- The first two cases of NICCD are described in infants from the UK, one of Caucasian and one of Pakistani origin. PMID: 19517266
- Compares and contrasts all the known human SLC25A* genes and includes functional information. PMID: 23266187
- The objectives were to study the prevalence of neonatal intrahepatic cholestasis caused by citrin deficiency (NICCD) in Thai infants with idiopathic cholestasis, mutation spectrum of SLC25A13 in Thai NICCD, and comparison of clinical manifestations and blood chemistry between NICCD and non-NICCD infants. PMID: 23067347
- uncovered the marked transcript diversity of SLC25A13 gene in human PBLs, and suggested that cDNA cloning analysis of this gene in human PBLs might be a feasible tool for CD molecular diagno PMID: 23022256
- Mutations in SLC25A13 are associated with citrin deficiency. PMID: 22277121
- In 171 suspected patients, seven neonatal intrahepatic cholestasis caused by citrin deficiency patients were detected by HRM. PMID: 22487826
- Functional studies, carried out on the recombinant mutant protein containing glutamate at position 437, demonstrated that neonatal intrahepatic cholestasis caused by citrin deficiency is caused by a reduced transport activity of SLC25A13 PMID: 21914561
- Case Report: suggest that the administration of arginine and sodium pyruvate with low-carbohydrate meals may be an effective therapy in patients with citrin deficiency. PMID: 18958581
- individuals with non-viral HCC were more likely to possess SLC25A13 gene mutations compared to healthy subjects PMID: 21470889
- this study expanded the genotypic and phenotypic spectrum of citrin deficiency. PMID: 21424115
- SLC25A13 gene mutations play an important role in Chinese infants with intrahepatic cholestasis and various forms of aminoacidemia; 851del4 and 1638ins23 are the most common mutation types PMID: 20927635
- Seven genetic variations of SLC25A13, termed as 851del4, 1638ins23, IVS16ins3kb, IVS6+5G>A, c.775C>T (p.Q259X), c.1505C>T (p.P502L) and c.1311C>T (p.C437C), were identified PMID: 21507300
- The SLC25A13 mutations may not be a major contributor to the pathogenesis of hepatocellular carcinoma in Taiwan. PMID: 21134364
- MDR analysis provided evidence of interaction between the genes for ASS1 and SLC25A13 on the risk of CL/P. PMID: 20739017
- Four hundred infants with unexplained intrahepatic cholestasis from 18 China were studied for detecting SLC25A13 gene mutation 851del4. Eight homozygous and 30 heterozygous mutations were detected in 46 mutant alleles with a 851del4 mutation rate of 5.8%. PMID: 20458766
- We report three unrelated Malay children with genetically confirmed neonatal intrahepatic cholestatic caused by citrin deficiency characterised by an insertion mutation IVS16ins3kb in SLC25A13 gene PMID: 20614727
- SLC25A13 gene mutations exist in Chinese infants with intrahepatic cholestasis and abnormal blood amino acids. PMID: 18578996
- The historical aspects of citrin and citrin deficiency, characteristic food preference and food aversion of citrin-deficient subjects, and carbohydrate toxicity in relation to ureogenesis, is described. PMID: 20233664
- The 851del4, 1638ins23 and IVS6+5G>A mutations are the hot-spot mutations in Chinese patients with neonatal intrahepatic cholestasis caused by citrin deficiency. PMID: 20376801
- genetic screening of mutations in early and late onset patients with citrin deficiency and in the Japanese population: identification of two novel mutations and establishment of multiple DNA diagnosis methods for nine mutations PMID: 11793471
- Adult-onset type II citrullinemia is caused by mutations of the SLC25A13 gene PMID: 12111366
- Citrullinemia is a metabolic disorder characterized by elevated plasma concentrations of citrulline and ammonia. Adult-onset citrullinemia (type II, CTLN2) has been attributed to citrin deficiency caused by mutations in the SLC25A13 gene. PMID: 17000460
- Analysis of citrin protein in peripheral blood lymphocytes is useful to diagnose citrin deficiency in patients without known mutations or hypercitrullinemia. PMID: 17092749
- This report describes the clinical characteristics, biochemical findings and molecular analysis of the SLC25A13 gene of patients with citrin deficiency in Korea. PMID: 17982687
- report 13 novel SLC25A13 mutations (one insertion, two deletion, three splice site, two nonsense, and five missense) in patients with citrin deficiency from Japan, Israel, UK, and Czech Republic PMID: 18392553
- Patients presenting with non-alcoholic fatty liver unrelated to obesity and metabolic syndrome might have citrin deficiency, caused by SLC25A13 gene mutations. PMID: 18620775
- 5 novel mutations were found in SLC25A13 from three unrelated French-Canadian Citrin deficiency patients. PMID: 19036621
- Results of this study showed, even during the silent period, sustained hypercitrullinemia, hypercholesterolemia, and augmented oxidative stress in children with citrin deficiency. PMID: 19232506
- 851del4/1638ins23 mutations in a Chinese adult onset type II citrullinaemia patient PMID: 11432966
顯示更多
收起更多
-
相關(guān)疾病:Citrullinemia 2 (CTLN2); Cholestasis, neonatal intrahepatic, caused by citrin deficiency (NICCD)
-
亞細(xì)胞定位:Mitochondrion inner membrane; Multi-pass membrane protein.
-
蛋白家族:Mitochondrial carrier (TC 2.A.29) family
-
組織特異性:High levels in liver and low levels in kidney, pancreas, placenta, heart and brain.
-
數(shù)據(jù)庫(kù)鏈接:
Most popular with customers
-
-
YWHAB Recombinant Monoclonal Antibody
Applications: ELISA, WB, IHC, IF, FC
Species Reactivity: Human, Mouse, Rat
-
-
-
-
-
-